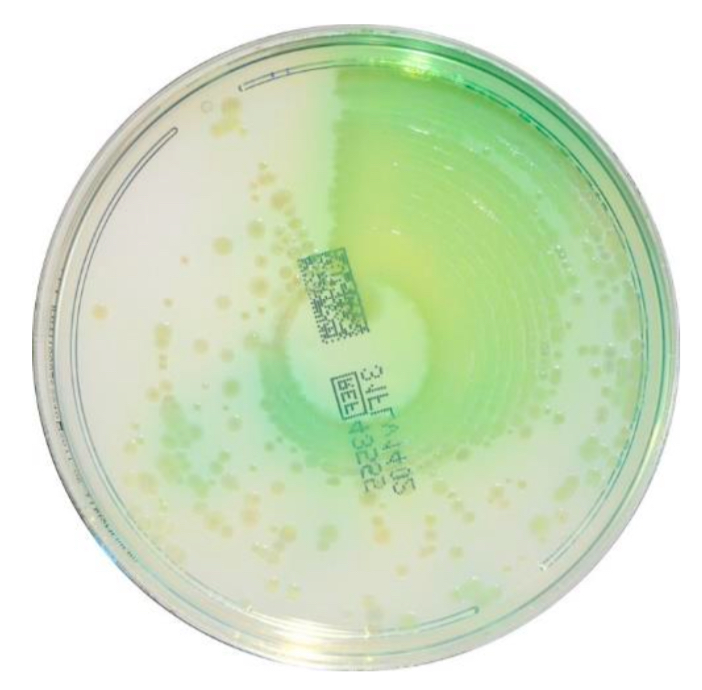

Cetrimide Agar
1/10
There's no tags or description
Looks like no tags are added yet.
Name | Mastery | Learn | Test | Matching | Spaced |
|---|
No study sessions yet.
11 Terms
what type of agar is cetrimide agar?
selective

what is the selective agent in cetrimide?
cetrimide (disinfectant/antiseptic that pseudomonas is resistant to)

what does cetrimide agar test for?
pseudomonas
principle of CET
inhibits most bacteria; enhances growth and green pigment production by P. aeruginosa which produces pigments like pyocyanin and fluorescein

what pigments does pseudomonas produce?
pyocyanin and fluorescein
which pigment causes the blue color of the colonies on CET?
pyocyanin

which pigment causes the yellow color and fluorescence of the colonies on CET?
pyoverdine
what does certrimdie inhibit?
most bacteria
what does growth and a green color on cetrimide mean?
it is pseudomonas
will appear green because of pyocyanin pigment production
what does NO growth and a green color on cetrimide mean?
it is not pseudomonas, it is something else

what does pseudomonas demonstrate under UV light?
fluorescence